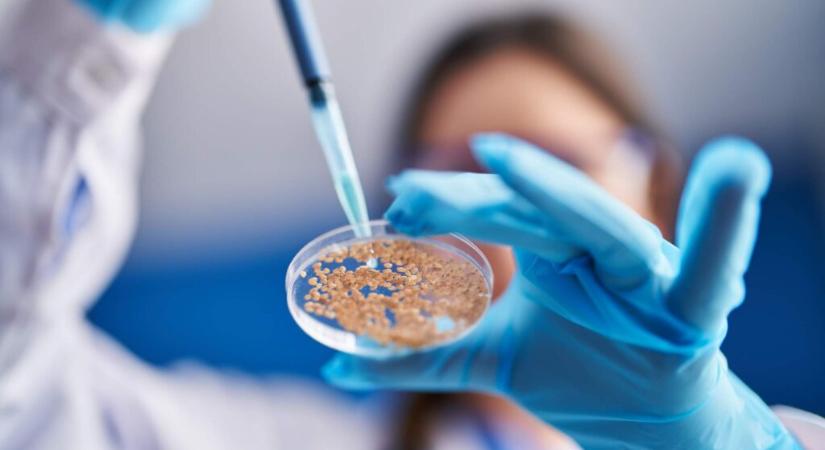
ISTA workshopot tartanak Budapesten

ISTA workshopot tartanak Budapesten
Gyakorlatorientált nemzetközi szakmai workshopnak ad otthont Budapest március 17-20. között a Nemzetközi Vetőmagvizsgáló Szövetség (ISTA), a Nemzeti Élelmiszerlánc – biztonsági Hivatal (Nébih), valamint az Alisca-Mag Kft. szervezésében. A négynapos szakmai program célja, hogy a 15 országból érkező, összesen 33 résztvevő számára részletes ismerteket nyújtson a vetőmag-mintavétel gyakorlatáról, valamint az ehhez kapcsolódó minőségbiztosítási követelményekről a különböző […] A ISTA workshopot tartanak Budapesten bejegyzés először Agrotrend-én jelent meg.
- Hirdetés -